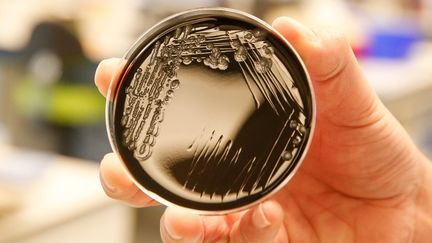
Légionellose : 17 cas confirmés en Savoie et une vingtaine de suspicions de cas, selon l'ARS Auvergne-Rhône-Alpes

Pour plus de la moitié des personnes contaminées, “il y avait un facteur de risque qui était recensé”, précise l’ARS.
Sign in
Welcome! Log into your account
Forgot your password? Get help
Password recovery
Recover your password
A password will be e-mailed to you.